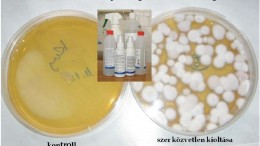

Az ajurvédikus táplálkozás és a jóga-egy kis ízelítő a hagyományos keleti gyógyítás világából
Bevezetés Korunkban az alternatív medicina egyre nagyobb szerepet kap a betegségek megelőzésében és számos idült betegség kiegészítő kezelésében. Az ájurvéda átfogó rendszere – beleértve a speciális táplálkozást és a rendszeres jógagyakorlást – meglehetősen gyorsan terjed….